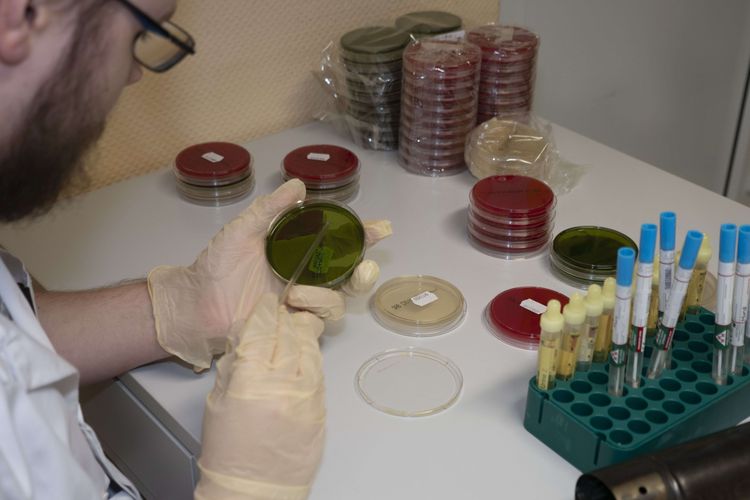

Ausbildung Gesundheits- und Krankenpflegehelfer/in (m/w/d)
Strukturierte Ausbildung mit Theorie- und Praxisanteilen
Praxisplätze in Krankenhäusern und Pflegeeinrichtungen
Persönliche Betreuung durch Lehrkräfte
Moderne Unterrichtsmethoden
Finanzielle Unterstützung durch den Ausbildungsträger
Perspektive für die weiterführende Pflegeausbildung
Hauptschulabschluss oder mittlerer Bildungsabschluss
Interesse an medizinischen und pflegerischen Tätigkeiten
Teamfähigkeit und Belastbarkeit
Verantwortungsbewusste Arbeitsweise
Freundlicher Umgang mit Patientinnen und Patienten
Unterstützung bei der Pflege von Patient:innen
Messen von Vitalzeichen
Hilfe bei Untersuchungen und Behandlungen
Durchführung von Hygienemaßnahmen
Dokumentation pflegerischer Tätigkeiten
Für diesen Schritt brauchen wir noch eine gültige E-Mail-Adresse von dir. Bitte hinterlege sie in deinem Account.
Schon erledigt.